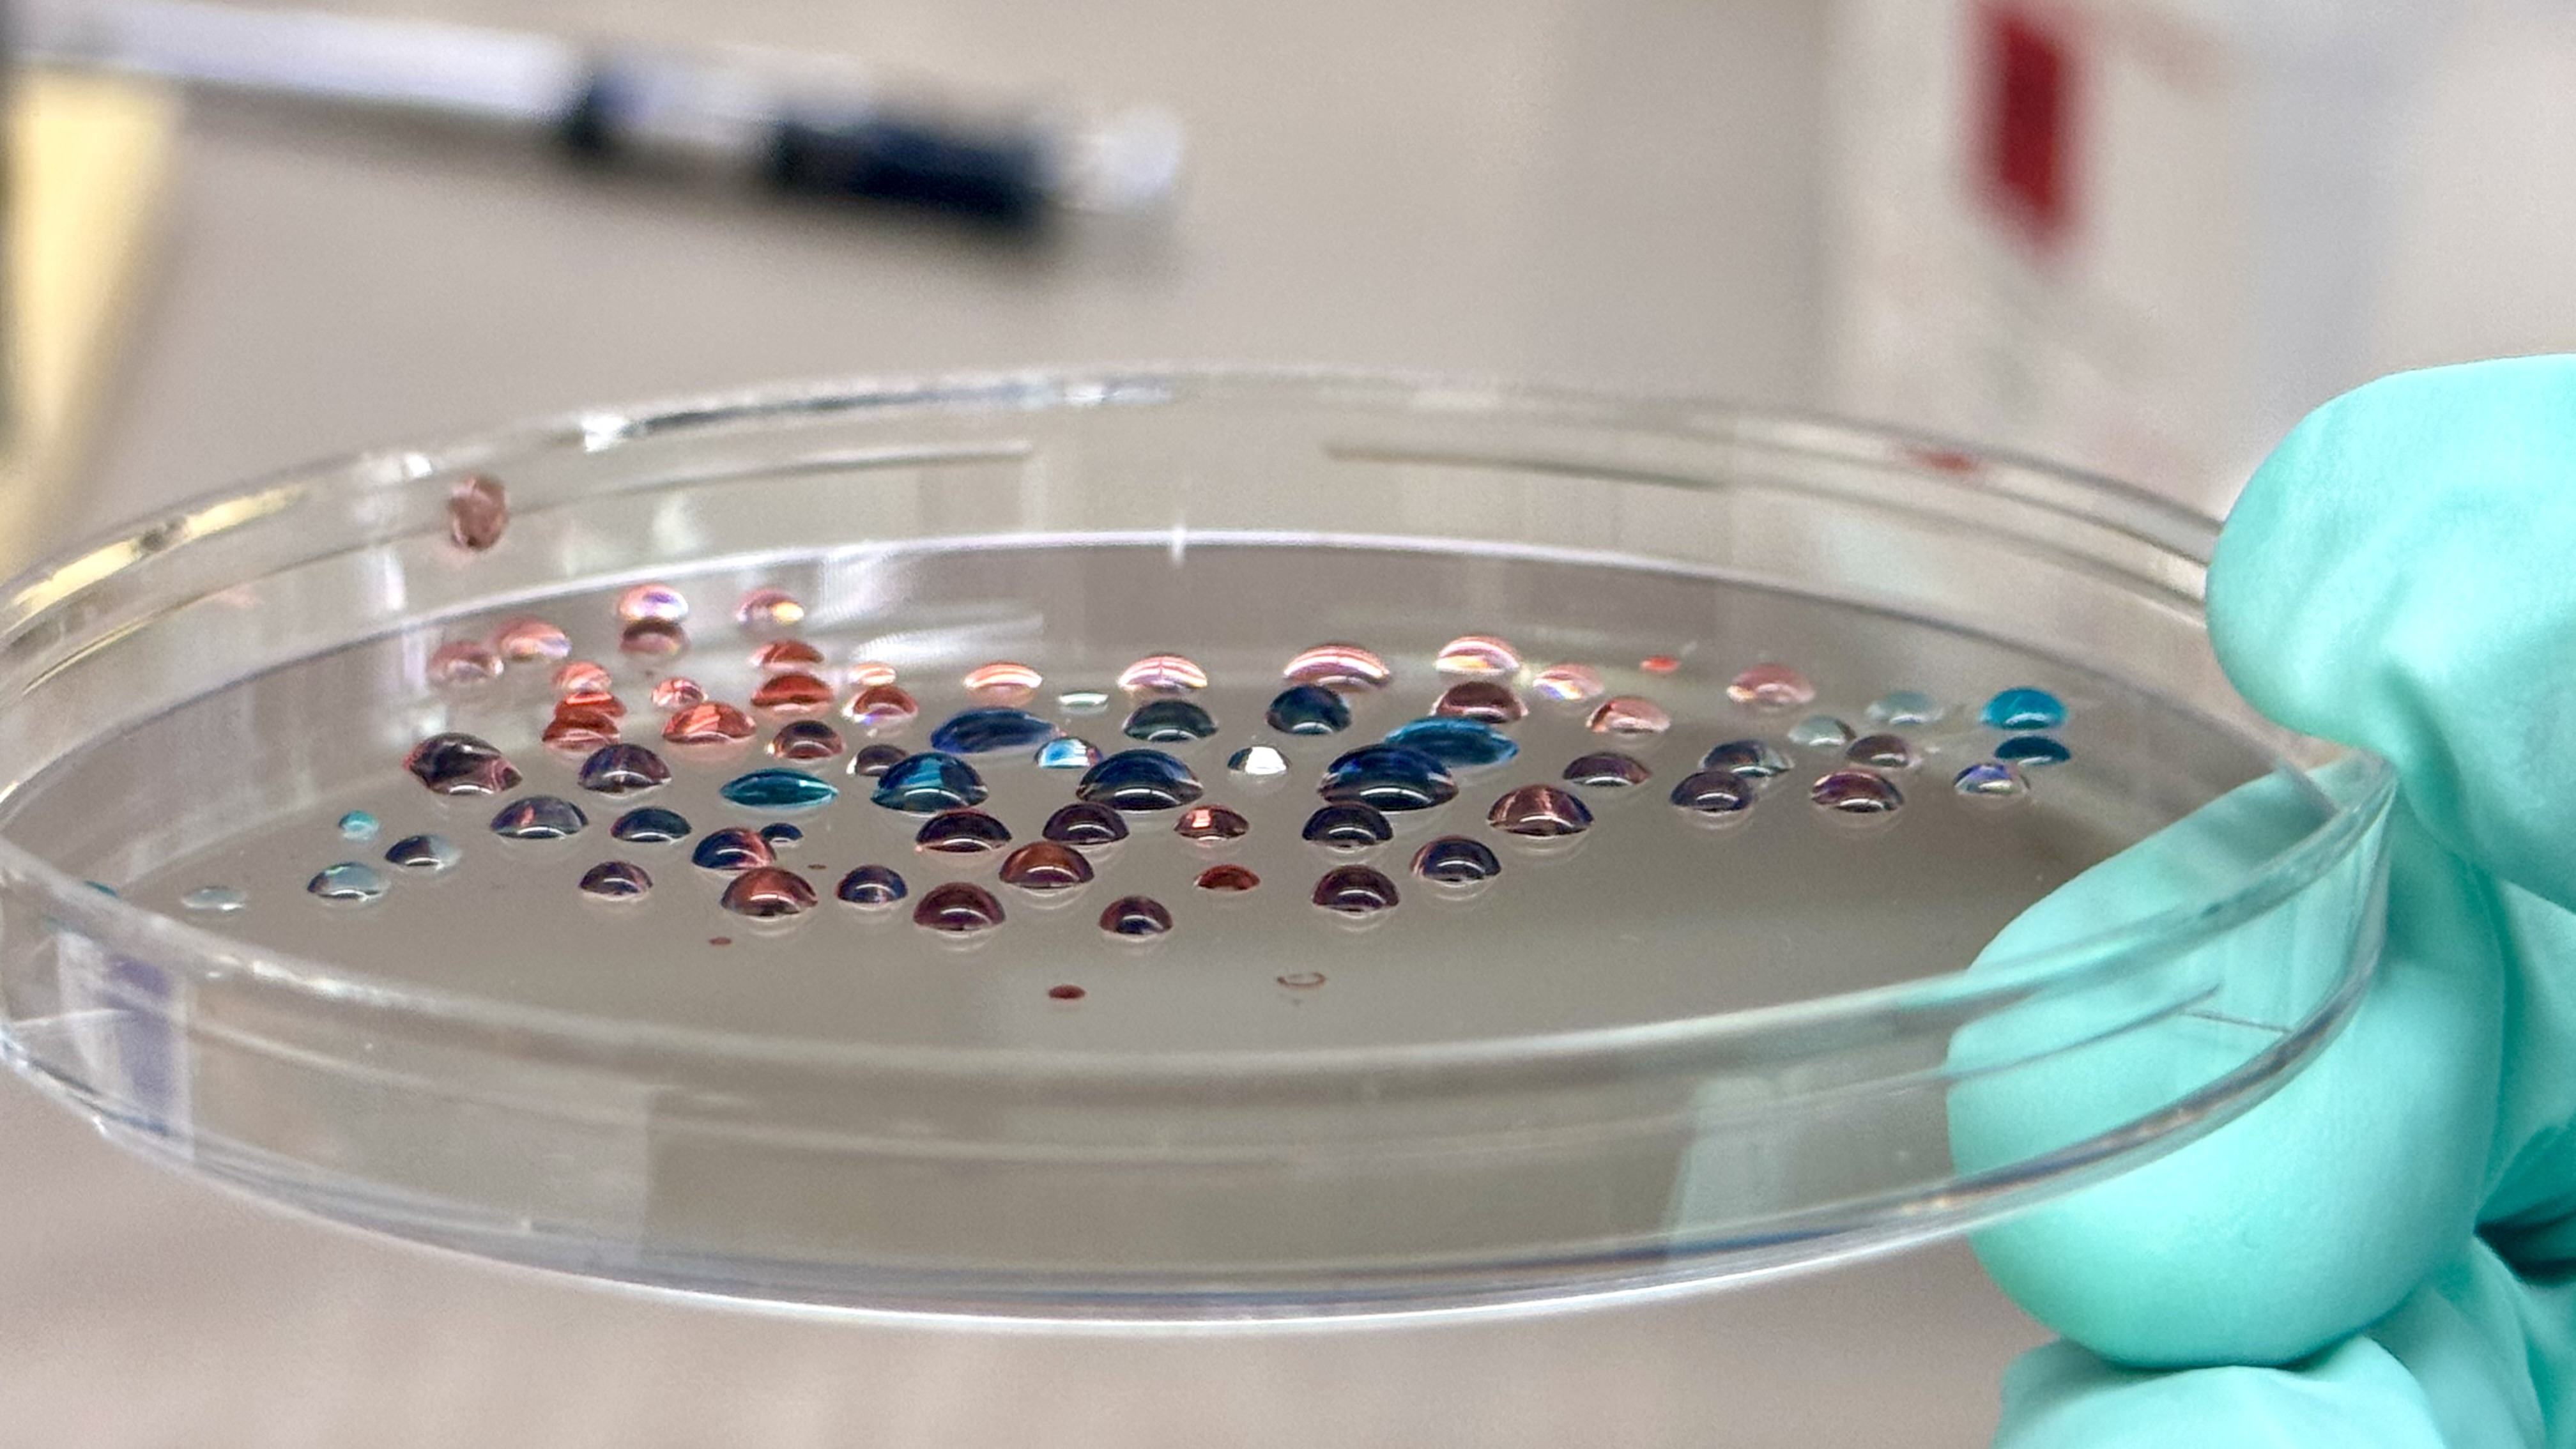
Cover Image
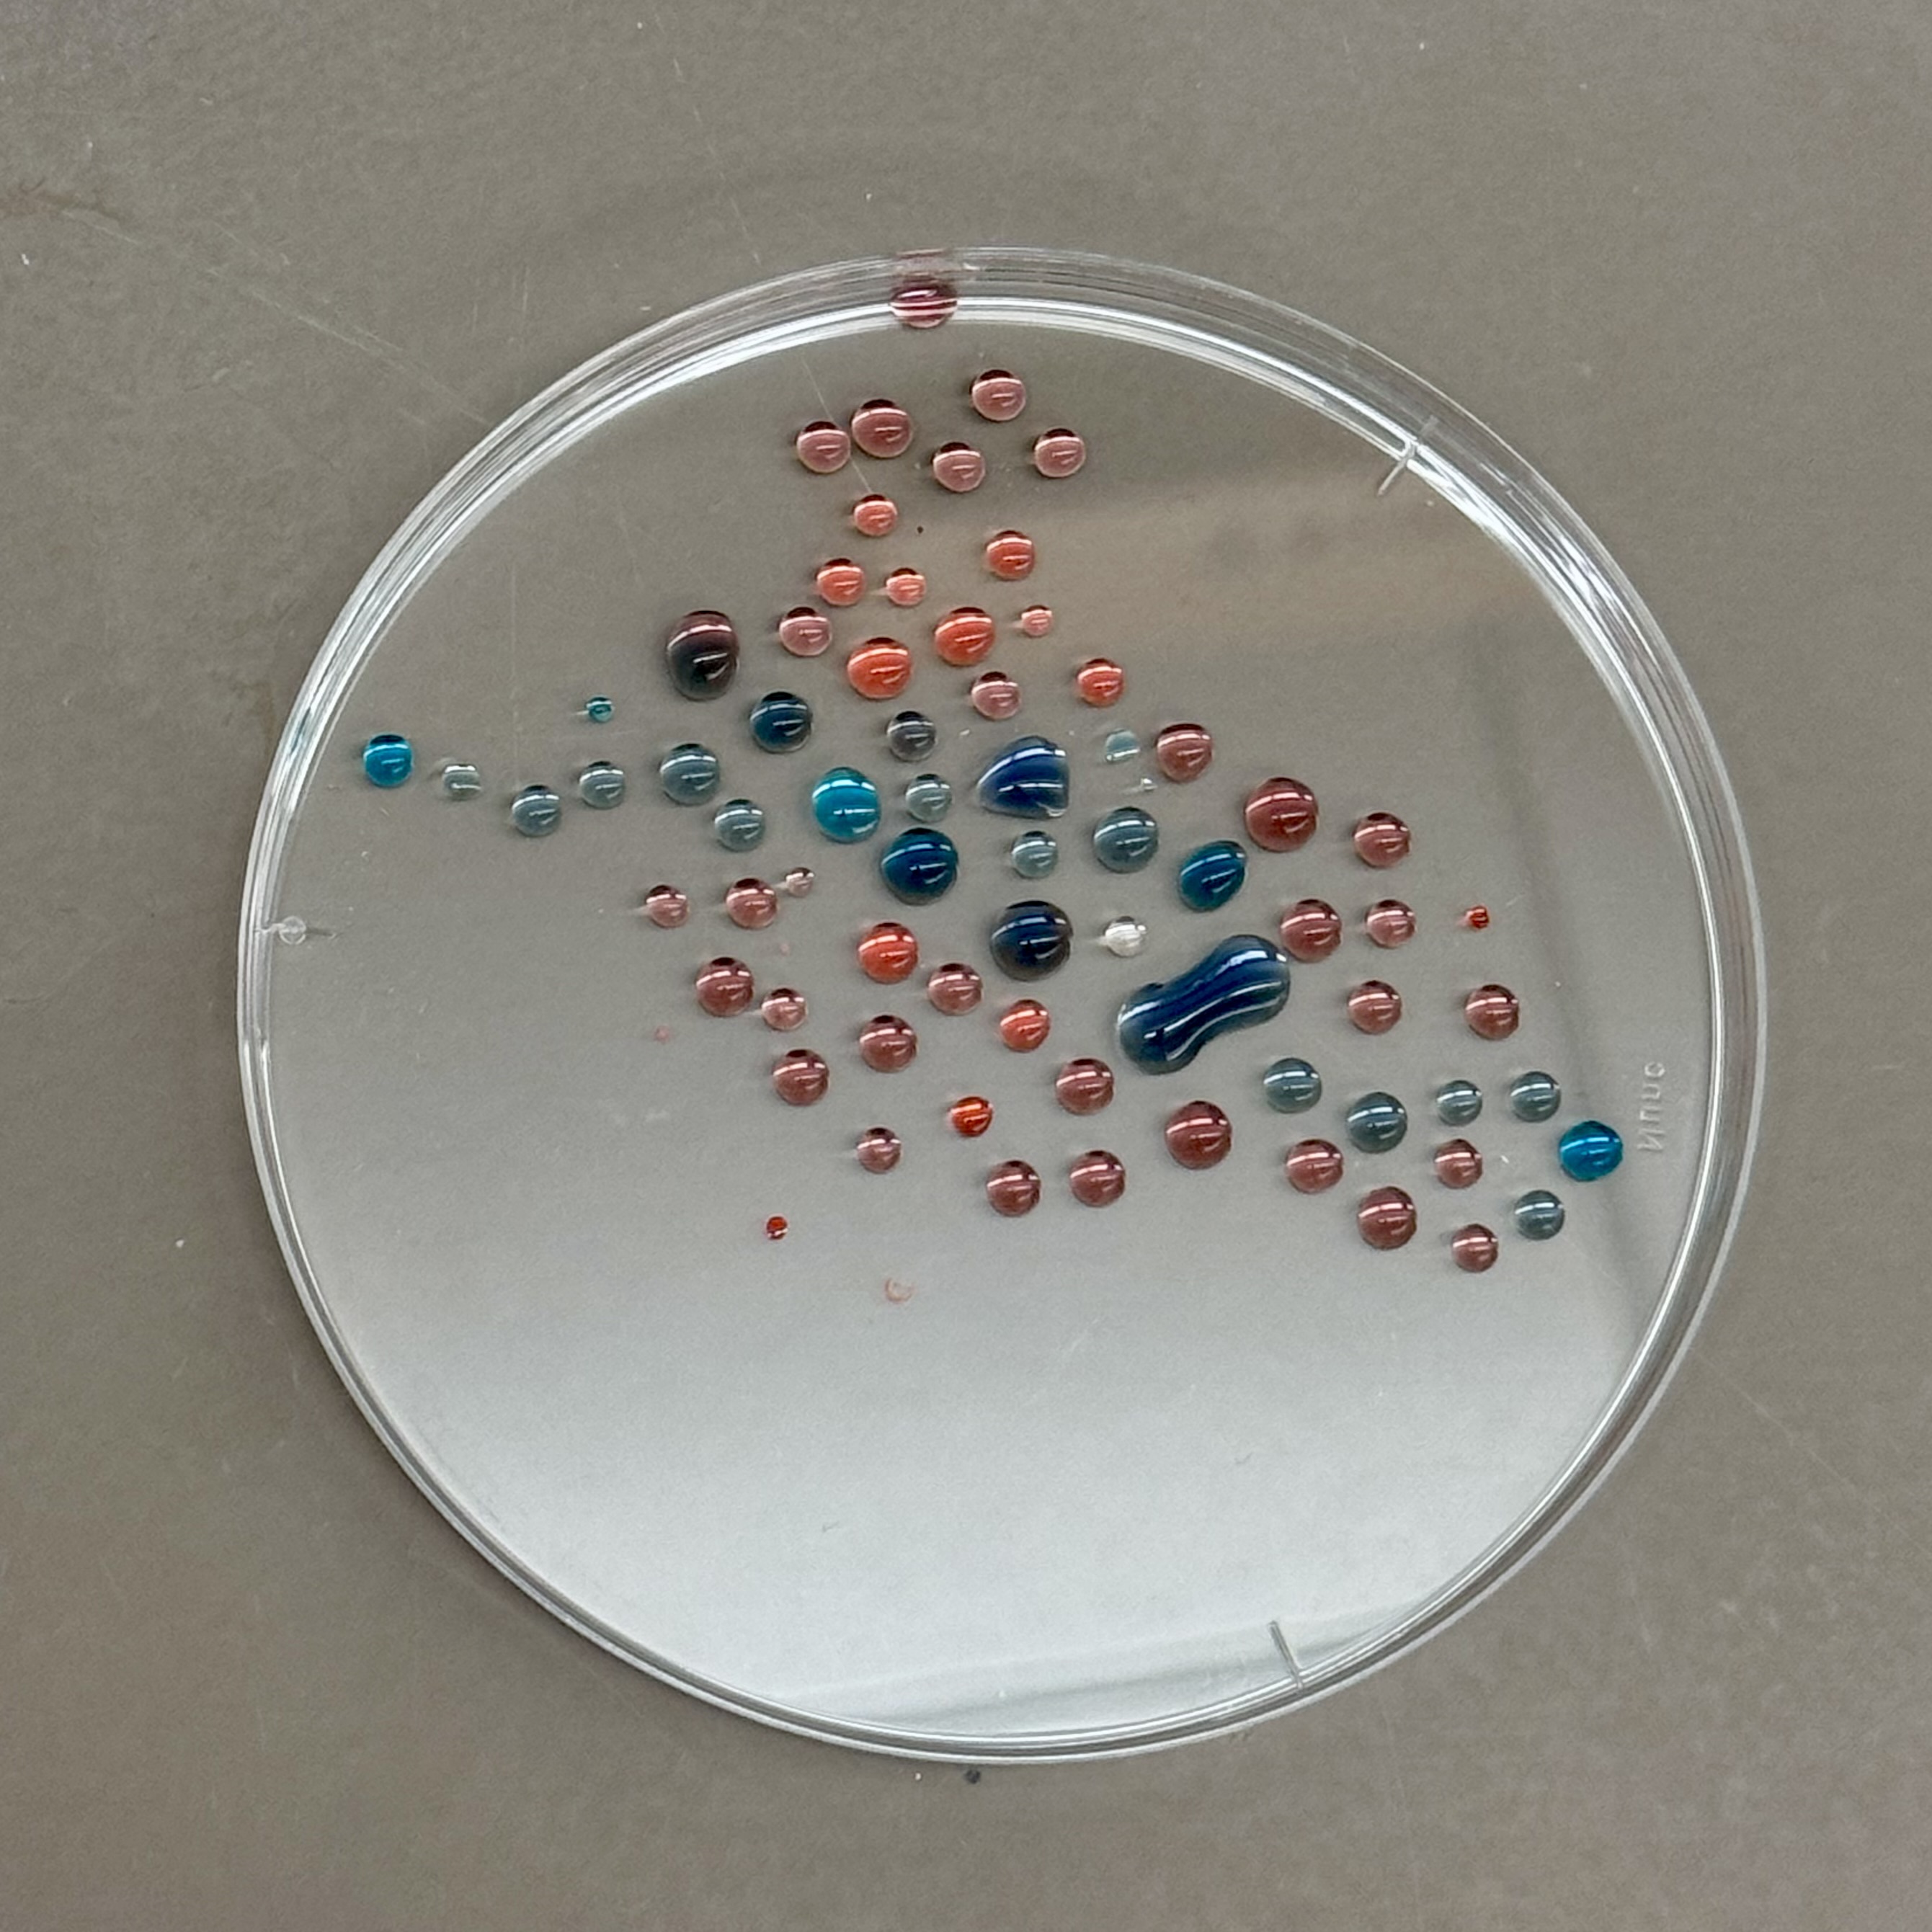
Final Pipetting Art

Subsections of <Yanchen Shen> — HTGAA Spring 2026
Homework
Weekly homework submissions:
Week 1 HW: Principles and Practices
Governance and Ethical Framework for Astro-Moss and Bio-textiles.
Week 2: DNA Read, Write, & Edit
DNA Design Challenge 3.1 Protein Choice I chose pHluorin (superecliptic pHluorin, SEP) because it makes pH changes visible as a clear signal. pH is a broadly meaningful indicator across scales: it can reflect cellular and bodily conditions (e.g., local acidity in compartments or stress-related microenvironments) and also environmental conditions (e.g., water/soil toxicity or chemical shifts). This makes SEP useful not only as a biosensing concept, but also as an interaction metaphor. Even small changes in conditions can switch what becomes visible.
Subsections of Homework
Week 1 HW: Principles and Practices

Image credit: John Game via Wikimedia Commons
1. Bio-Engineering Application: Astro-Moss
Project Vision
I propose the development of Astro-Moss, a engineered strain of Physcomitrium patens designed for extreme environmental resilience. By leveraging the high genomic editability of moss, this project aims to create varieties capable of surviving extreme diurnal temperature fluctuations, high ionizing radiation, and desiccation.
Applications
- Extraterrestrial Foundation: Serving as a primary “pioneer” vegetation for Martian habitats to build organic substrate for future crops.
- Functional Bio-textiles: Extracting engineered cells or fibers to create “living” textiles for astronaut apparel that offer self-repairing properties and radiation shielding, contributing to long-term sustainability in space exploration.
2. Governance and Policy Goals
To ensure this application contributes to an ethical future, I have defined the following goals based on the framework of promoting constructive use while minimizing harm:
- Goal 1: Ensure Biosafety and Security. Preventing the unintended release of engineered extremophiles into Earth’s ecosystems or the misuse of resilience genes.
- Sub-goal 1.1: Biocontainment. Implement failsafes to ensure Astro-Moss cannot survive outside controlled habitats.
- Sub-goal 1.2: Dual-use Oversight. Screen genetic sequences related to extreme resistance to prevent their use in enhancing harmful pathogens.
- Goal 2: Promote Equity and Global Autonomy. Ensuring that the foundational tools for space colonization are not monopolized by a single entity.
- Sub-goal 2.1: Open Standards. Establish international protocols for safety data sharing.
- Sub-goal 2.2: Technology Access. Ensure community biolabs and international researchers can contribute to and benefit from the project.
3. Governance Actions Matrix
| Aspect | Action 1: Technical Biocontainment | Action 2: DNA Synthesis Screening | Action 3: Open-Source Safety Alliance |
|---|---|---|---|
| Purpose | Engineering “kill-switches” or auxotrophy, dependency on lab-only nutrients. | Mandatory screening of synthetic DNA orders. | Voluntary international consortium to share safety protocols and risk assessments. |
| Design | Actors: Academic researchers and firms. Must be integrated into the R&D phase. | Actors: Commercial providers and federal regulators. | Actors: International firms, NGOs, and UN. |
| Assumptions | Assumes mutation will not bypass the switch. | Assumes use of regulated synthesis channels. | Assumes safety over proprietary advantages. |
| Risks | Failure: Evolution of bypass mechanisms. Success: May limit moss adaptability in genuine emergencies. | Failure: Use of benchtop synthesizers. Success: Increases cost and time for R&D. | Failure: Soft law without enforcement may be ignored. Success: Establishes a global culture of responsibility. |
4. Detailed Scoring Matrix
Score: 1 (Best/Most effective) to 3 (Least effective/Most problematic)
| Does the option: | Option 1 | Option 2 | Option 3 |
|---|---|---|---|
| Enhance Biosecurity | |||
| • By preventing incidents | 2 | 1 | 2 |
| • By helping respond | 1 | 3 | 1 |
| Foster Lab Safety | |||
| • By preventing incident | 1 | 2 | 1 |
| • By helping respond | 1 | N/A | 1 |
| Protect the environment | |||
| • By preventing incidents | 1 | 2 | 2 |
| • By helping respond | 1 | 3 | 1 |
| Other considerations | |||
| • Minimizing costs and burdens to stakeholders | 3 | 2 | 1 |
| • Feasibility? | 2 | 1 | 3 |
| • Not impede research | 3 | 2 | 1 |
| • Promote constructive applications | 2 | 2 | 1 |
5. Prioritization, Recommendation, and Ethical Reflections
Target Audience: The United Nations Office for Outer Space Affairs (UNOOSA) and the International Space Exploration Coordination Group (ISECG).
Recommendation Strategy: I prioritize a Hybrid Governance Model that mandates Technical Biocontainment (Action 1) as a prerequisite for mission approval, supported by an International Open-Source Safety Alliance (Action 3) to manage global compliance, safety standards, and equity.
Justification based on Scoring: While DNA Screening (Action 2) provides an immediate defensive layer, our scoring matrix reveals its significant failure in Response and Equity. For a frontier technology like Astro-Moss, we cannot rely on blocking orders alone.
- Action 1 is prioritized because it offers intrinsic safety; a biological kill-switch ensures that even if a containment breach occurs on Earth or a target planet, the organism’s impact is self-limiting.
- Action 3 is essential to prevent the safety requirements of Action 1 from becoming a proprietary wall. By open-sourcing safety modules, we ensure that the Right to Explore remains equitable across all nations.
Ethical Trade-offs Considered:
- Safety vs. Adaptability: The most robust kill-switch inherently limits the moss’s ability to evolve and survive in truly unknown extraterrestrial variables. I am consciously trading off mission success probability for guaranteed planetary protection.
- Innovation Speed vs. Regulation: Mandatory international oversight through an Alliance will slow the deployment of Bio-textiles. However, the risk of a Forward Contamination event (accidentally destroying potential Martian microbial life) would set the entire field of synthetic biology back by decades due to the resulting ethical crisis and public outcry.
Assumptions and Uncertainties:
- Assumption of Genetic Stability: This strategy assumes that the complex kill-switch will not be silenced by the high-radiation environments of space. If the mutation rate exceeds our containment design, the technical strategy fails.
- Uncertainty of Extraterrestrial Interaction: We lack data on how engineered genes might interact with potential Martian life. This unknown unknown makes the Biological Footprint Audit (drawing from the DIYBio expert model) a critical necessity to ensure independent, peer-reviewed validation of every mission’s biocontainment integrity.
Week 2 Lecture Prep
Homework Questions from Professor Jacobson
Q1: Nature’s machinery for copying DNA is called polymerase. What is the error rate of polymerase? How does this compare to the length of the human genome. How does biology deal with that discrepancy?
Native DNA polymerase has a baseline error rate of approximately 10-7 to 10-8 per base pair. When combined with biological proofreading and mismatch repair mechanisms, the final error rate is reduced to about 10^-10. Given the human genome consists of 3.2 billion base pairs, these high fidelity repair systems ensure that fewer than one error occurs per replication cycle. Biology utilizes these multi layered verification systems to bridge the gap between high data volume and required synthesis accuracy.
Q2: How many different ways are there to code (DNA nucleotide code) for an average human protein? In practice what are some of the reasons that all of these different codes don’t work to code for the protein of interest?
For a protein of average length, the redundancy of the genetic code allows for over 10^190 different DNA sequence combinations. In practice, the vast majority of these sequences are non functional. Major constraints include codon usage bias leading to translation stalls, the formation of complex mRNA secondary structures that block ribosomal movement, and the accidental creation of regulatory motifs or splice signals that interfere with proper expression.
Homework Questions from Dr. LeProust
Q1: What’s the most commonly used method for oligo synthesis currently?
The most widely utilized method currently is phosphoramidite chemical synthesis.
Q2: Why is it difficult to make oligos longer than 200nt via direct synthesis?
The primary barrier is that the coupling efficiency of each synthesis step never reaches 100 percent. As the nucleotide chain grows, cumulative errors cause the final product yield to drop exponentially. This results in an accumulation of truncated sequences that make the target full length sequence extremely difficult to isolate.
Q3: Why can’t you make a 2000bp gene via direct oligo synthesis?
Direct chemical synthesis of a 2000bp gene results in a yield that is effectively zero. The standard industry approach involves synthesizing multiple shorter oligonucleotide fragments and then using enzymatic assembly techniques to stitch them into a complete gene.
Homework Questions from George Church
Q1: What are the 10 essential amino acids in all animals and how does this affect your view of the “Lysine Contingency”?
The ten essential amino acids for animals are phenylalanine, valine, threonine, tryptophan, isoleucine, methionine, histidine, arginine, leucine, and lysine.
Lysine contingency as a biological safety measure is fundamentally fragile. Since lysine is already a naturally essential amino acid for animals, engineering an organism to be unable to synthesize it merely replicates a natural state rather than adding a secure safeguard. In real world environments, engineered organisms can easily bypass this restraint by consuming lysine from common plants or animal tissues. Effective biocontainment should instead rely on synthetic dependencies not found in nature. An example is semantic containment where organisms require non canonical amino acids provided only in a controlled lab setting to ensure they cannot survive in the wild.
Week 2: DNA Read, Write, & Edit
DNA Design Challenge
3.1 Protein Choice
I chose pHluorin (superecliptic pHluorin, SEP) because it makes pH changes visible as a clear signal. pH is a broadly meaningful indicator across scales: it can reflect cellular and bodily conditions (e.g., local acidity in compartments or stress-related microenvironments) and also environmental conditions (e.g., water/soil toxicity or chemical shifts). This makes SEP useful not only as a biosensing concept, but also as an interaction metaphor. Even small changes in conditions can switch what becomes visible.
3.2 Reverse Translate: Protein (amino acid) sequence to DNA (nucleotide) sequence.
To obtain the precise nucleotide sequence for superecliptic pHluorin (SEP), I performed a targeted search and retrieval process using the NCBI:
- Protein Identification: I accessed the official NCBI Protein record for superecliptic pHluorin (SEP) under accession number AAS66682.1.
- Nucleotide Record Location: On the protein record page, I utilized the “Nucleotide sequence from coding region” link found under the Related information sidebar. This link redirected me to the NCBI Nucleotide (nuccore) entry AY533296.1, titled “Synthetic construct superecliptic pHluorin mRNA, complete cds”.
- CDS Feature Selection: Within the nuccore page, I specifically identified the CDS (coding region) segment to isolate the exact sequence responsible for protein translation.
- FASTA Retrieval: I displayed the sequence in FASTA format (ensuring the header line starts with
>) to maintain compatibility with downstream design tools. - Sequence Capture: I copied the nucleotide CDS sequence (bases 1..717) as the foundational DNA template for the SEP protein.
- 3.2 & 3.3 Reverse Translation & Optimization: The sequence was reverse-translated and codon-optimized for E. coli expression to ensure high yield while avoiding Type IIs restriction sites (BsaI, BsmBI, BbsI).
- DNA Sequence:
Prepare a Twist DNA Synthesis Order
I designed an expression cassette to be synthesized as a clonal gene.
- Design Components: J23106 Promoter, B0034 RBS, Optimized sfGFP, 7xHis Tag, and B0015 Terminator.
- Vector Selection: pTwist Amp High Copy. This circular backbone allows for direct transformation into E. coli, speeding up the experimental cycle by 1-2 weeks.

Figure 1: Annotated sfGFP expression cassette designed in Benchling.
Part 5: DNA Read/Write/Edit
Inspired by Marina Otero Verzier’s theory, this documentation explores a move away from the Cartesian enclosure of traditional data centers. I propose using Engineered Moss as a living fabric and information archive for extraterrestrial exploration.
5.1 DNA Read: Material Entanglement
- Technology: Nanopore Sequencing.
- Vision: Reading the Moss. This transcends binary retrieval; it is an act of “touching a leaf” to listen to the archive. Nanopore allows us to decode how cosmic radiation and human interaction have “co-written” the DNA, creating a material entanglement where the building, the document, and the environment are one.
5.2 DNA Write: The Breathing Library
- Technology: Enzymatic DNA Synthesis.
- Vision: Encoding human collective memory into moss spores.
- Theory: This breaks the “myth of endless growth.” Moss archives are non-hierarchical; as they flourish on alien regolith, they capture CO2 and produce oxygen. It is an architecture that “makes breath possible”—an archive that is both alive and gives life.
5.3 DNA Edit: Ontological Freedom
- Technology: CRISPR/Cas9.
- Vision: Editing moss for extreme desiccation and radiation tolerance.
- Ethics: This edit is not an extractive tool for profit. We grant the moss ontological freedom to express its agency in a new world. It is an act of solidarity and cohabitation between species, allowing the “Data Forest” to germinate in the inconceivable futures of space.
Labs
Lab writeups:
Pipetting Art In Week 1 Lab, I practiced pipetting process by creating art with colored dyes on a petri dish. This exercise helped me master volume control and steady hand movement.
- Liquid Preparation and Mixing Techniques During this stage, I learned how to distinguish the precision ranges of different pipettes and how to adjust the volume for each. I practiced the proper operational sequence for aspirating liquid without contaminating the source and dispensing it into Eppendorf tubes. Additionally, I practiced the blow-out and mixing techniques using the pipette to ensure consistent color density across my palette.
Overview In this lab, I focus on the practical application of DNA restriction digestion and agarose gel electrophoresis. The goal is to design and create DNA gel art by using selected restriction enzymes to generate DNA fragments of specific lengths, then resolving those fragments on a gel to form an image. For this experiment, I aim to produce a “boring face” (—_—) pattern.
Image credit: HTGAA 2026 Lab: Opentrons Artwork In this week’s lab, I made two custom Opentrons OT-2 protocols and used the liquid-handling robot to print Fluorescent E. coli onto black (charcoal) agar plates. I produced two pieces using different design workflows:
Subsections of Labs
Week 1 Lab: Pipetting
Pipetting Art
In Week 1 Lab, I practiced pipetting process by creating art with colored dyes on a petri dish. This exercise helped me master volume control and steady hand movement.
01. Liquid Preparation and Mixing Techniques
During this stage, I learned how to distinguish the precision ranges of different pipettes and how to adjust the volume for each. I practiced the proper operational sequence for aspirating liquid without contaminating the source and dispensing it into Eppendorf tubes. Additionally, I practiced the blow-out and mixing techniques using the pipette to ensure consistent color density across my palette.

02. Workspace Setup
A glimpse of the workspace: the bench is equipped with Distilled Water and features various pieces of “Pipetting Art” created by myself and my classmates. Maintaining an organized area is essential for a smooth workflow during the creative process.

03. Final Pipetting Art
This is the final composition created by controlled droplets. Each dot represents a specific volume dispensed with careful pressure on the pipette plunger, showcasing the result of repetitive precision practice.
Week 2 Lab: DNA Gel Art

Overview
In this lab, I focus on the practical application of DNA restriction digestion and agarose gel electrophoresis. The goal is to design and create DNA gel art by using selected restriction enzymes to generate DNA fragments of specific lengths, then resolving those fragments on a gel to form an image. For this experiment, I aim to produce a “boring face” (—_—) pattern.
Part 1: In-silico Design
Before entering the lab, I iterated on the target pattern using Ronan’s Automation Art website and used Benchling to simulate how Lambda DNA (48,502 bp) would be cleaved by selected restriction enzymes. This digital preparation enabled me to anticipate the expected banding patterns on the agarose gel and provided a reference for later interpretation of the experimental results.
1.1 Artistic Mapping and Enzyme Selection
For this experiment, I assigned specific enzymes to represent different facial features based on the fragment sizes they produce:
- EcoRV and PvuII: forms the outer “ ( ) ” boundaries.
- SacI: creates the eye bands “ — ”.
- SalI: creates the mouth band “ _ ”.

1.2 Virtual Gel Prediction
I used Benchling’s virtual gel tool to verify that the fragments for the eyes, mouth, and face boundaries would migrate to the intended relative positions. The simulation confirmed that the selected enzymes should produce a clear, distinguishable “boring face” pattern on the agarose gel. The required restriction-digest reagents and volumes were generated using the Automation Art website and used as the setup guide for the subsequent wet lab procedure.

Part 2: Wet-lab Experiment
2.1 Restriction Digest
I prepared restriction digests using Lambda DNA and 10X CutSmart buffer for all reactions. Enzymes were added last.
- DNA: Lambda DNA
- Buffer: 10X CutSmart
- Enzymes: restriction enzymes
- Incubation: 37°C, 40 min
2.2 Gel Electrophoresis
I used a 1% agarose gel and loaded the digested samples into the wells.
- Voltage: 130V
- Time: 40 mins
2.3 Deviation
The intended mouth lane (lane 5) in Benchling was Lambda_DNA_Thermo_(NC_001416) + SalI. Due to an Automation Art configuration error, the corresponding wet-lab reaction was prepared without SalI.

3. Results and Observations
3.1 The Final Gel Art
3.2 Failures & Reflections
In the final gel, lanes 4 and 6 most closely matched the expected composite pattern in terms of band position and clarity. Lane 5 produced a visible band, but it likely reflects a setup error rather than the intended condition: in Benchling, the “mouth” lane was designed as Lambda_DNA_Thermo_(NC_001416) + SalI, but a mid-process misconfiguration in Automation Art propagated into the wet-lab setup, and the corresponding reaction was prepared without SalI (buffer + λ DNA added, SalI omitted). Lanes 3 and 7 did not yield a legible gel-art “image” in this run (lane 3 shows the ladder; lane 7 is faint).
Compared with the exported gel image, the raw transilluminator photo shows weaker contrast: the ladder lane is faint but detectable, and only the central lanes show distinct bands near the wells; the rest of the gel has low signal with a visible dye front.
Issue 1: Low Overall Fluorescence and Weak Contrast
- Observation: The raw transilluminator photo displayed weaker contrast compared to the exported gel image. Overall band visibility was low across most lanes.
- Speculation: Shared Lambda DNA and enzymes were frequently handled and moved between storage and benches by multiple users. Repeated freeze thaw cycling likely reduced enzyme activity or DNA quality. Potential cross contamination during shared reagent handling may have also affected reaction performance.
Issue 2: Inconsistent Lane Clarity in Lanes 4 and 6
- Observation: Only lanes 4 and 6 produced clear bands that closely matched the expected composite pattern. Lane 7 appeared faint compared with lanes 4 and 6.
- Speculation: Lane 4 contained a higher volume of loading dye which likely improved sample density and helped it settle consistently in the well to increase visibility. In weaker lanes, small sample volumes between 2 to 5 microliters may have remained inside pipette tips during loading. Furthermore, differences in loading dye volume can change apparent intensity even when the digest chemistry is identical.
Issue 3: Design Mismatch in Lane 5
- Observation: Lane 5 produced a visible band but failed to represent the intended mouth pattern using SalI as specified in the Benchling design.
- Speculation: Lane 5 was prepared without SalI enzyme. This error likely originated from an initial configuration mistake in the Automation Art tool that propagated into the wet lab setup. Omitting the enzyme produced a band pattern that naturally does not match the prediction for the mouth feature.
Issue 4: Poor Resolution in the Lower Gel Half
- Observation: A prominent dye front was visible but the lower half of the gel contained limited resolved band information.
- Speculation: Running the electrophoresis at 130V for 40 minutes was likely too aggressive for smaller fragments. High voltage may have reduced the resolution of shorter DNA segments and pushed them toward or beyond the dye front before they could be clearly separated.
Issue 5: Buffer Limitations
- Observation: All digestion reactions were performed using a single CutSmart buffer.
- Speculation: While utilizing one universal buffer is convenient for all digests, it may have resulted in sub optimal cutting performance for specific enzymes or enzyme combinations that require different salt concentrations for maximum activity.
Week 3 Lab: Lab Automation
Image credit: HTGAA 2026
Lab: Opentrons Artwork
In this week’s lab, I made two custom Opentrons OT-2 protocols and used the liquid-handling robot to print Fluorescent E. coli onto black (charcoal) agar plates. I produced two pieces using different design workflows:

Design 1: Flower (Python protocol)
I explored how Python-defined coordinates translate into the OT-2 end-effector path, and how pipetting settings—especially volume—shape the deposited pattern and later bacterial growth. I used three fluorescent strains: Cyan (mTurquoise2), Yellow (Venus), and Red (mRFP). Cyan and Yellow followed two perpendicular ∞ (infinity) paths that together read as a flower-like form; their paths overlap at the center to test color mixing and spatial blending between strains. For Red, I mainly adjusted single-dispense volume to compare the “growth radius” suggested by the code with the actual colony spread on the plate. Two Red deposit points were placed to intersect with the Cyan/Yellow geometry to further test mixed-color effects at intersections.
Python Script:
Simulation:

UV-illuminated Petri Dish:

Design 2: Birds (Automation Art)
To learn the Opentrons Arts pipeline, I used the Automation Art Interface: I imported an illustration, adjusted it in the web editor, published the design to the gallery, and then had the TA download and run it in the Opentrons App for automated pipetting. This workflow let me compare the constraints and benefits of a GUI-based image-to-path process versus direct protocol scripting.
Automation Art Design & Simulation:

UV-illuminated Petri Dish:

Part 2: Post Lab Questions
Q1: Find and Describe
HYdrogel Dispensing method with Robotic Automation (HYDRA) for HTS-compatible hydrogels.
In this publication, the authors show how liquid handling automation can be used as a fabrication method, not just as a pipetting convenience. They introduce an automated workflow called HYDRA that makes thin and planar hydrogel films directly inside standard multiwell plates, so the resulting cell culture substrate is compatible with high throughput screening and imaging.
HYdrogel Dispensing method with Robotic Automation (HYDRA) for HTS-compatible hydrogels. Torchia, E., Di Sante, M., Horda, B. et al. Fabrication of cell culture hydrogels by robotic liquid handling automation for high-throughput drug testing. Commun Eng 4, 222 (2025). https://doi.org/10.1038/s44172-025-00575-3
Research Question
High-throughput screening (HTS) usually uses rigid plastic/glass, which reduces physiological relevance. Hydrogels improve biomimicry, but in multiwell plates they often form curved menisci that interfere with uniform seeding and microscopy, and many hydrogel approaches end up too thick for high-resolution imaging.
Lab Automation
HYDRA’s key trick is a dispense + immediate re-aspiration routine: the robot dispenses a sub-contact volume of hydrogel precursor (avoiding sidewall wetting), then re-aspirates to “pin” the contact line and leave a uniform micrometric film on the well bottom (reported ~10–50 µm). This produces meniscus-free coatings that remain compatible with standard 96- and 384-well workflows.
In their methods, the authors explicitly use an OT-2 as an “entry-level” open-source platform to demonstrate accessibility for academic labs: they implement casting via Opentrons Protocol Designer, using controlled dispense/aspirate heights and flow rates (e.g., dispensing at hundreds of microns above the bottom and aspirating closer to the surface) to reliably leave a thin residual layer that later crosslinks.
Biological Application
They fabricate fish-gelatin hydrogels crosslinked with microbial transglutaminase, then validate the platform with imaging-based dose–response assays (e.g., nocodazole and paclitaxel) on engineered epithelial cells, showing the hydrogel substrates support long-term holographic imaging and fluorescence microscopy while preserving expected pharmacological readouts.
Q2: Lab Automation Plan for Final Project
For my final project on improving extreme-environment tolerance for moss-based DNA storage, I plan to use a cloud laboratory workflow (Ginkgo Nebula) to run a high-throughput screening matrix with strong reproducibility and minimal manual pipetting.
Cloud-lab automation plan:
To systematically identify the most resilient variants and protective environments for our moss-based sensors, I utilize an automated screening workflow to test multiple tolerance-enhancement conditions in parallel:
- Precision Arraying (Echo Transfer): I will use the Echo Acoustic Liquid Handler to precisely array various tolerance-enhancement sets—including diverse pHluorin variants, protective additives (e.g., trehalose), and specific cofactors—into designated wells of 96 or 384-well plates.
- Stressor Distribution (Bravo & MultiFlo): The Bravo Automated Liquid Handling Platform and MultiFlo FX Dispenser are employed to distribute master mixes and stressor reagents (such as $H_2O_2$ for oxidative stress) across the plates, creating controlled gradients of UV, desiccation, and chemical stressors.
- Environmental Control (PlateLoc & Inheco): Plates are sealed using the PlateLoc Thermal Microplate Sealer to prevent evaporation, followed by incubation in Inheco modules. This ensures rigorous control over temperature and timing during both the stress-induction and recovery phases.
- Automated Access (XPeel): Between multi-step stages, transitioning from stress to recovery or preparing for measurement, the XPeel system automates the removal of seals, allowing for seamless integration without manual intervention.
- Performance Analysis (PHERAstar): Finally, the PHERAstar Plate Reader measures fluorescence (specifically the pH-dependent excitation shifts of pHluorin) and absorbance. This serves as a post-stress performance proxy, allowing me to rank conditions based on signal retention and metabolic recovery.



















